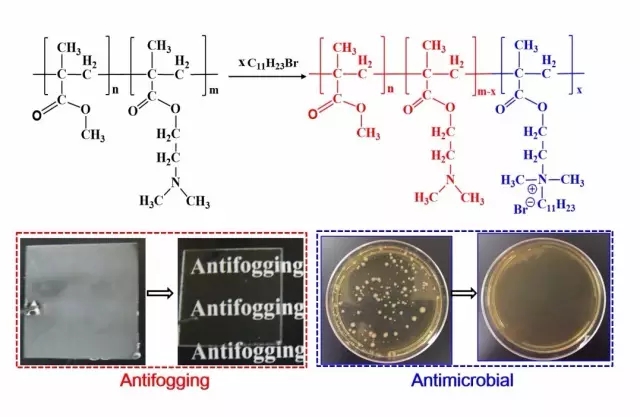
1.webp.jpg

雾滴的形成与存在严重阻碍光线透过,不仅会给人类生活、生产带来诸多不便,在一些特定领域诸如医用设备中,普遍存在的镜头雾化现象可造成镜像模糊,进而干扰正常手术处理,甚至能引发严重的医疗事故。目前采用的镜头喷涂防雾液虽然能起到临时的防护效果,却在长期反复使用过程有着诸多不便。因此,具有高效持久性的防雾涂层在医疗领域具有重大的意义。与此同时,赋予永久性防雾涂层高效非释放型的杀菌性能,减少、杜绝致病细菌的侵入与感染,保障医用设备正常、安全地使用,具有着广泛的需求空间。
图1防雾抗菌表面涂层的制备原理
美国佐治亚南方大学明伟华课题组赵杰博士等创造性地构建了由亲/疏水链段组成的半贯穿高分子网络涂层,获得既非超亲水亦非超疏水的防雾抗菌性涂层材料(图1)。区别于传统型超亲水抗雾表面,此类材料巧妙利用涂层表面吸水性与溶胀性微妙平衡,使到达涂层表面的雾滴被快速吸收,达到防雾抗霜目的(图2)。

图2 水滴在涂层表面接触角及润湿半径动态变化趋势
同时,由于将杀菌性的疏水季铵盐基团以共价链接的方式引入到高分子链上,在不改变材料亲/疏水性平衡的基础上,赋予了涂层材料非释放性的高效杀菌性能(5-log, total kill的杀菌效率)。最终使得涂层材料兼具高效防雾性与抗菌性。此种方法具有制备过程简化,使用性广泛等诸多优势。
原文赏析
Dual-Functional Antifogging/Antimicrobial Polymer Coating
Dual-functional antifogging/antimicrobial polymer coatings were prepared by forming a semi-interpenetrating polymer network (SIPN) of partially quaternized poly(2-(dimethylamino)-ethylmethacrylate-co-methylmethacrylate) and polymerized ethylene glycol dimethacrylate network. The excellent antifogging behavior of the smooth coating was mainly attributed to the hydrophilic/hydrophobic balance of the partially quaternized copolymer, while the covalently bonded, hydrophobic quaternary ammonium compound (5mol% in the copolymer) rendered the coating strongly antimicrobial, as demonstrated by the total kill against both Gram-positive Staphylococcus epidermidis and Gram-negative Escherichia coli. The antimicrobial action of the SIPN coating was based on contact killing, without leaching of bactericidal species, as revealed by a zone-of-inhibition test. This type of dual-functional coating may find unique applications where both antimicrobial and antifogging properties are desired.
原文链接
Zhao J, Ma L, Millians W, et al. Dual-Functional Antifogging/Antimicrobial Polymer Coating.[J]. ACS Applied Materials & Interfaces, 2016. DOI: 10.1021/acsami.6b00748
责任编辑:周娅
《中国腐蚀与防护网电子期刊》征订启事
投稿联系:编辑部
电话:010-62313558-806
邮箱:ecorr_org@163.com
中国腐蚀与防护网官方 QQ群:140808414
免责声明:本网站所转载的文字、图片与视频资料版权归原创作者所有,如果涉及侵权,请第一时间联系本网删除。
官方微信
《腐蚀与防护网电子期刊》征订启事
- 投稿联系:编辑部
- 电话:010-62316606
- 邮箱:fsfhzy666@163.com
- 腐蚀与防护网官方QQ群:140808415



